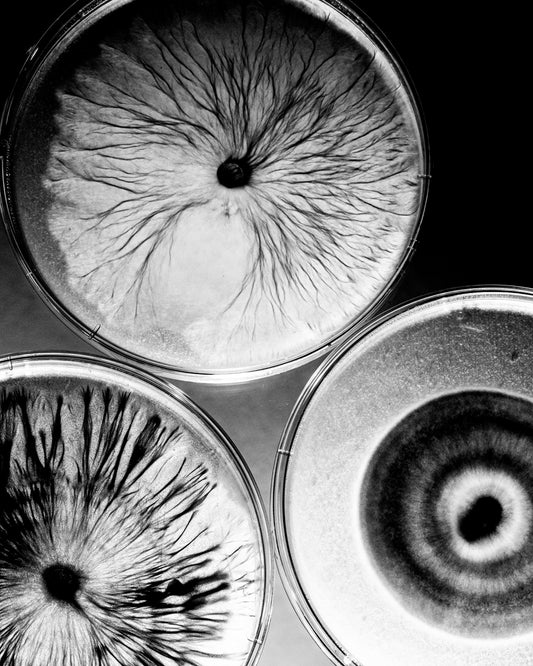

-
Nora's View
Regular price From $400.00 USDRegular priceUnit price / per -
Before the Next Chapter
Regular price From $350.00 USDRegular priceUnit price / per -
Mother Earth #5
Regular price From $400.00 USDRegular priceUnit price / per -
Run Alice, Run
Regular price From $400.00 USDRegular priceUnit price / per -
Penelope Waits
Regular price From $400.00 USDRegular priceUnit price / per -
Maybe Tomorrow Will Be
Regular price From $400.00 USDRegular priceUnit price / per -
The Masks We Wear
Regular price From $400.00 USDRegular priceUnit price / per -
Life Satisfaction
Regular price From $400.00 USDRegular priceUnit price / per -
January Mud
Regular price From $400.00 USDRegular priceUnit price / per -
Introverted
Regular price From $400.00 USDRegular priceUnit price / per -
Liquid Souls
Regular price From $400.00 USDRegular priceUnit price / per -
Vacant Hearts
Regular price From $500.00 USDRegular priceUnit price / per -
Legasuarus 1
Regular price From $400.00 USDRegular priceUnit price / per -
Garage M.02
Regular price From $400.00 USDRegular priceUnit price / per -
Garage M.01
Regular price From $400.00 USDRegular priceUnit price / per -
Spring Grass
Regular price From $400.00 USDRegular priceUnit price / per